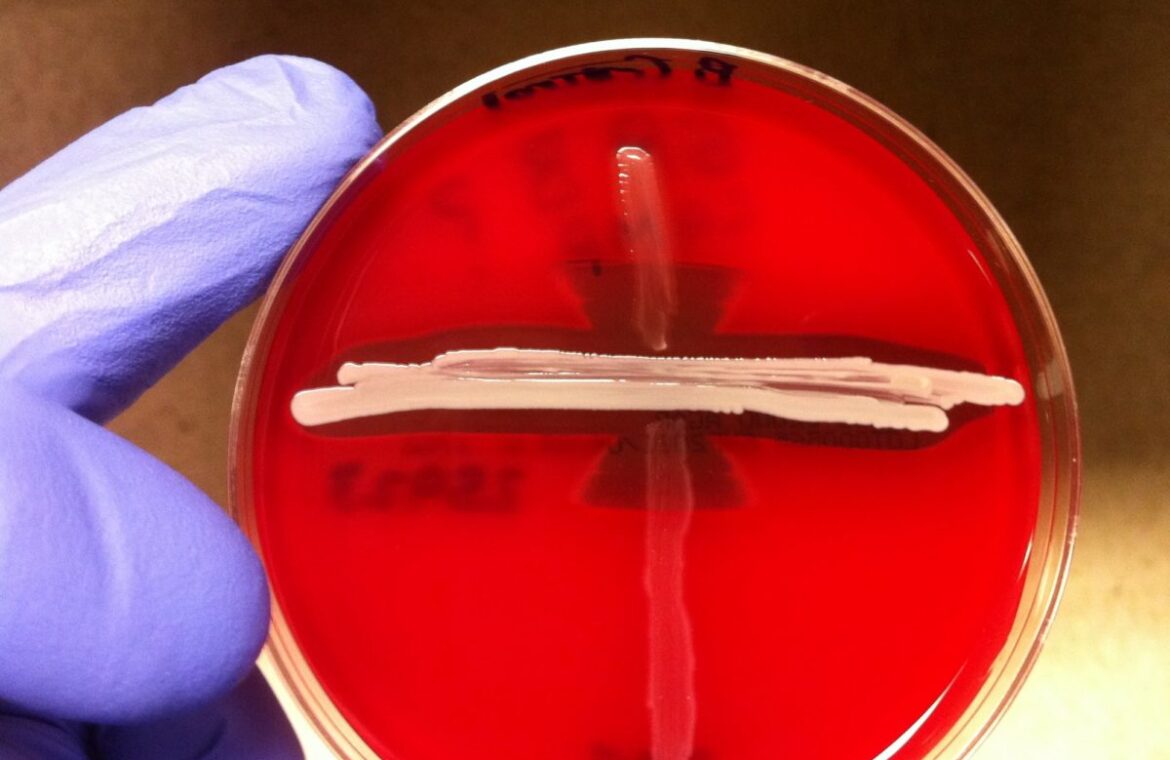

Σήμα κινδύνου για τις ενδονοσοκομειακές λοιμώξεις στέλνει το Ευρωπαϊκό Κέντρο Ελέγχου Λοιμώξεων ECDC, καθώς στη χώρα μας παρατηρείται ραγδαία άνοδος των ανθεκτικών μικροβίων με την αύξηση της κλεμπσιέλλας κατά 38%, του κολοβακτηριδίου κατά 54,7% και του ανθεκτικού σταφυλόκοκκου κατά 8,2%.
Την ίδια στιγμή, η χώρα μας κατατάσσεται στην 3η θέση από πλευράς κατανάλωσης αντιβιοτικών και αντιμικροβιακών φαρμάκων συνολικά, σε σύγκριση με τις λοιπές ευρωπαϊκές χώρες.
Τα στοιχεία αυτά περιλαμβάνονται στις πρόσφατες εκθέσεις του ECDC για την μικροβιακή αντοχή στην Ευρώπη και τις δράσεις που πρέπει να αναληφθούν για την αντιμετώπισή τους.
Την τρίτη θέση στην κατανάλωση αντιμικροβιακών μετά τη Σλοβακία και τη Βουλγαρία κατέλαβε η χώρα μας

Σταφυλόκοκκος aureus ανθεκτικός σε διάφορα αντιβιοτικά
Σύμφωνα με την έκθεση για την μικροβιακή αντοχή, στην οποία για πρώτη φορά περιλαμβάνονται στοιχεία από όλες τις χώρες της Ευρώπης, τα πιο συχνά βακτήρια το 2022 ήταν τα εξής:
- Escherichia coli (39,2%)
- Staphylococcus aureus (22,1%),
- Klebsiella pneumoniae (12,3%),
- Enterococcus faecalis (8,2%),
- Pseudomonas aeruginosa (6,1%),
- Enterococcus faecium (5,9%),
- Streptococcus pneumoniae (3,7%) και
- Acinetobacter spp. (2,5%).
Με βάση τα παραπάνω ποσοστά, διαπιστώνεται άνοδος της ψευδομονάδας και του στρεπτοκόκκου πνευμονίας σε σύγκριση με το 2021.
Το Συμβούλιο της Ε.Ε. στο πλαίσιο του προγράμματος «Ενιαία Υγεία» (One Health) έχει θέσει ως στόχους για το 2030 τη μείωση της μικροβιακής αντοχής και μείωση της συχνότητας των λοιμώξεων της κυκλοφορίας ανθεκτικών μικροβίων στο αίμα, κατά 15% στον ανθεκτικό στη μεθικιλλίνη σταφυλόκοκκο aureus (MRSA), κατά 10% στο ανθεκτικό στην κεφαλοσπορίνη τρίτης γενιάς E. coli (κολοβακτηρίδιο) και κατά 5% στην ανθεκτική στην καρβαπανέμη κλεμπσιέλλα πνευμονίας, σε σύγκριση με τα περιστατικά του 2019.
Στη νέα έκθεση, βάσει των στοιχείων του 2022, οι λοιμώξεις της κυκλοφορίας του αίματος στην ΕΕ παρουσίασαν μείωση στον ανθεκτικό στη μεθικιλλίνη σταφυλόκοκκο MRSA και στο ανθεκτικό κολοβακτηρίδιο σε σύγκριση με το 2019, εντούτοις η ανθεκτική στην καρβαπανέμη κλεμπσιέλλα, αυξήθηκε σχεδόν κατά 50%.
Τα ποσοστά μικροβιακής αντοχής παραμένουν υψηλά στην ΕΕ/ΕΟΧ και προκαλούν ανησυχία, καθώς παρατηρείται συνεχής αύξηση της ανθεκτικής στην καρβαπενέμη Klebsiella pneumoniae (κατά 10,9% το 2022) και του ανθεκτικού στη βανκομυκίνη εντεροκόκκου E. faecium (κατά 17,6% το 2022 ).

Η έκθεση επισημαίνει τη μείωση του Acinetobacter spp. σε σύγκριση με το 2021, αλλά και τη σημαντικά αυξητική τάση στο μέσο ποσοστό αντοχής σε μακρολίδες και πενικιλίνη και του συνδυασμού τους στον στρεπτόκοκκο S. pneumoniae τα έτη 2018–2022.
Σε ότι αφορά τα τρία βασικά μικρόβια για τα οποία έχουν τεθεί οι στόχοι ως το 2030:
- Σταφυλόκοκκος ανθεκτικός στη μεθικιλλίνη. Στην Ευρώπη η συχνότητα των περιστατικών ήταν 5,63 ανά 100.000 πληθυσμού και στη χώρα μας 4,59 το 2019 και μέχρι πέρυσι η συχνότητα μειώθηκε κατά 12,2% στην Ευρώπη, ενώ στην Ελλάδα αυξήθηκε κατά 8,2%
- Κολοβακτηρίδιο (Escherichia coli) ανθεκτικό στις τρίτης γενιάς κεφαλοσπορίνες. Στην Ευρώπη η συχνότητα των περιστατικών το 2019 ήταν 10,42 ανά 100.000 πληθυσμού, έναντι 2,58 περιστατικά στην Ελλάδα. Μέχρι πέρυσι όμως, τα περιστατικά στην Ευρώπη μειώθηκαν κατά 16,8%, ενώ στη χώρα μας αυξήθηκαν κατά 54,7%
- Κλεμπσιέλλα πνευμονίας ανθεκτική στις καρβαπανέμες. Στην Ευρώπη η συχνότητα το 2019 ήταν 2,18 ανά 100.000 πληθυσμού, αλλά στην Ελλάδα τα περιστατικά έφταναν στα 13,05. Εδώ η αυξητική τάση ήταν κοινή, τόσο στην Ευρώπη, όσο και στη χώρα μας, με τα ποσοστά να φτάνουν σε 49,7% και 38%, αντίστοιχα.

E. coli σε καλλιέργεια ινοβλαστών
Κατανάλωση αντιβιοτικών
Την τρίτη θέση στην κατανάλωση αντιμικροβιακών μετά τη Σλοβακία και τη Βουλγαρία κατέλαβε η χώρα μας βάσει των στοιχείων του 2022, όμως όταν πρόκειται για θεραπείες από το φαρμακείο, εκεί η Ελλάδα κατέχει τα πρωτεία.
Όσον αφορά την κατανάλωση αντιμικροβιακών φαρμάκων για το 2022, για τη σύγκριση χρησιμοποιείται η κατανάλωση ημερησίων δόσεων ανά 1000 κατοίκους τόσο στην κοινότητα όσο και στα νοσοκομεία.
Η μέση κατανάλωση στην Ευρώπη ήταν 19,4 ημερήσιες δόσεις ανά 1000 κατοίκους, με τις χώρες να καταγράφουν ημερήσια κατανάλωση από 9,1 μέχρι 33,5 δόσεις. Από αυτές οι 17 δόσεις αφορούσαν θεραπείες κοινότητας με εύρος ημερήσιας κατανάλωσης από χώρα σε χώρα από 8,3–31,2 δόσεις.
Οι δόσεις αυτές είναι σημαντικά αυξημένες σε σύγκριση με τα δύο προηγούμενα χρόνια, όμως είναι σημαντικά μειωμένες σε σύγκριση με την προηγούμενη 10ετία. Στατιστικά σημαντική αυξητική τάση για 10 χρόνια παρατηρήθηκε στην Βουλγαρία και την Κύπρο.
Η μέση συνολική κατανάλωση αντιβακτηριακών για συστηματική χρήση μειώθηκε κατά 2,5% από το 2019 ως έτος αναφοράς, δείχνοντας μια αργή πρόοδο προς τον στόχο μείωσης της ΕΕ κατά 20% ως το 2030.
Δεν εντοπίστηκε στατιστικά σημαντική τάση κατά την πενταετία 2018–2022 για τη συνολική κατανάλωση (κοινοτικός και νοσοκομειακός τομέας μαζί) αντιμυκητιασικών για συστηματική χρήση.
Σε ότι αφορά τα νοσοκομεία, η μέση κατανάλωση ήταν 1,61 ημερήσια δόση ανά 1000 κατοίκους με εύρος από 0,75–3,15 δόσεις από χώρα σε χώρα, εμφανίζοντας σημαντική μείωση σε σύγκριση με την προηγούμενη 10ετία, αν και καταγράφηκε σημαντική αύξηση στη Βουλγαρία και την Κροατία.
Στην Ελλάδα, η κατανάλωση αντιμικροβιακών έφτανε τις 34,1 δόσεις το 2018 και 2019, μειώθηκε στις 28,1 δόσεις το 2020 και στις 23,5 δόσεις το 2021, ενώ πέρυσι επανήλθε στις 32,9 δόσεις για θεραπείες τόσο στην κοινότητα, όσο και στα νοσοκομεία. Συνολικά την τριετία εκτιμάται ότι έχει επέλθει μείωση της τάξης του 3,5%.
Πηγή: in.gr
❝ ετικέτες ❞ #ΑΝΤΙΒΙΟΤΙΚΑ